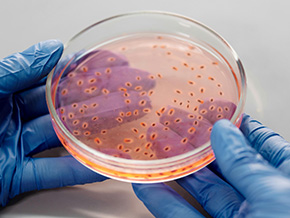

Researcher’s Night 2024!
The TwInn4MicroUp team had an amazing time sharing our passion for biotechnology and sustainability at Researcher’s Night annual event in Athens and in Bari

Establishment of a high-performance Research and Innovation Hub for Synthetic Microbial Biotechnology, elevating NTUA’s profile, addressing the innovation gap among the European Union countries, all the while delivering impactful socio-enviro-economic outputs via new circular petro- and bioplastics lifecycles.
Scientific community expansion
We have diverse and complementary backgrounds in enzyme biochemistry and biocatalysis, plastic recycling technologies, molecular genetics and biotechnology, synthetic biology and microbial engineering.
The creation of microbial cell factories, capable of producing significant quantities of valuable and innovative bioproducts through fermentation of plastic waste-derived feedstocks
Stay updated with our latest innovations, research breakthroughs, sustainability initiatives, and upcoming events and outreach efforts.
The TwInn4MicroUp team had an amazing time sharing our passion for biotechnology and sustainability at Researcher’s Night annual event in Athens and in Bari
We are proud to announce our participation in Researcher’s Night 2024, hosted by NTUA in Athens.
We are excited to kick off our EU Horizon-funded project on microbial plastic upcycling!